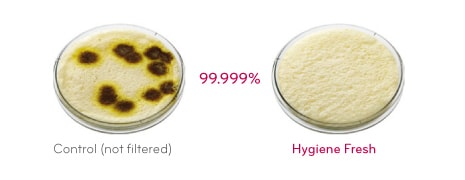
Bread test

AJOUTER À LA LISTE DE SOUHAITS
Ajoutez des articles à votre liste de souhaits MYLG
Voir la Liste de souhaits
Interrompu
GN-M562GLH
Copier le nom du modèle
Ce réfrigérateur classique tient dans votre cuisine et intègre également votre vie. Il peut gérer toute variété de nourriture avec amplement d'espace pour stocker
*titleText*
มีการคัดลอกชื่อรุ่น
Merci de voir le revendeur pour les prix
Vente en quantité limitée
Quantité disponible
*quantity* ea
-
Prix du produit(GN-M562GLH)
DT*rPrice*DT*rPromoPrice**discountPDPMsg*Prix des membres LG(GN-M562GLH)DT*rMemberPrice*DT*rMembershipPrice**discountPDPMsg*vip-price-message(GN-M562GLH)DT*rPrice*DT*rVipPrice**discountPDPMsg*OBS_CHEAPERPRICE_MSG DT*cheaperPrice*
Prix des membres LGDT*rMembershipPrice**rWelcomePriceDescription**rWelcomePriceTooltip*
DT*rWelcomePrice*
Total
MSRP
DT*improveTotalPrice*
MSRP
DT
Merci de voir le revendeur pour les prix
OBS_MEMBERSHIP_MSG DT*recommendedMembershipPrice*
┗ *modelName*
DT*discountedPrice*
*userFriendlyName*
bundle-unable-text
DT*discountedPrice*
économiser DT*discountPrice*
component-protectYour
0 component-selectedItems
*modelName*
DT*rPrice*.*rPriceCent*
DT*rPromoPrice*.*rPromoPriceCent*
*discountMsg*
OBS_LOWEST_PRICE_MARK_MSG
*retailerPricingText*
*modelName*
DT*rPrice*.*rPriceCent*
DT*rPromoPrice*.*rPromoPriceCent*
*discountMsg*
OBS_LOWEST_PRICE_MARK_MSG
*retailerPricingText*
Ce réfrigérateur classique tient dans votre cuisine et intègre également votre vie. Il peut gérer toute variété de nourriture avec amplement d'espace pour stocker
CAPACITÉ (ℓ / CU.FT.) - BRUT[SAA]
-
- Total
- 466
- Congélateur
- 142
-
- Réfrigérateur
- 324
CAPACITÉ (ℓ / CU.FT.) - [ISO]
-
- Total
- 428
- Congélateur
- 115
-
- Réfrigérateur
- 313
DIMENSION(MM)
-
- Net/Emballage - Largeur
- 755/819
- Net/Emballage - Hauteur
- 1777/1882
-
- Net/Emballage - Profondeur(avec Poignée)
- 707/750
- Net/Emballage - Profondeur(avec Poignée)
- 663/750
-
- Net/Emballage
- 85/90
- Net/Emballage - 20ft/ 40ft / 40ft HC
- 21/43/61
FONCTIONNALITÉS GÉNÉRALES
-
- Contrôle Temp. - Electronique (Capteur)
- Oui
- Refroidissement USP - Green Ion Door Cooling( Catchein)
- Oui
-
- Panneau Affichage - 88 LED / Bouton Tactile
- Oui (Vert)
- Filtre Hygiène
- Oui
-
- Alarme Porte
- Oui
- Porte - Serrure à clé
- Oui
-
- Roller - Normal comme CS
- Oui
COMPARTMENT RÉFRIGÉRATEUR
-
- Multi-Air Flow
- Oui
- Étagère - Verre trempé
- Oui
-
- Étagère - Full
- 2
- Étagère - Cover TV
- Oui
-
- Clayette - Transparente
- Oui (4)
- Clayette - Transparente (Moitié Taille-Panier)
- 2
-
- Clayette - Séparateur (Emplacement Bouteille)
- 1
- Coin Laitier - Plein / Moitié
- Oui
-
- Coin Laitier - Plateau d'œufs 1 nos.
- Oui
COMPARTIMENT DE CONGÉLATION
-
- Étagère - Verre trempé / Plastique
- Plastic
- Étagère - Full
- 1
-
- LED (Module / Capsule)
- Oui
UNE QUESTION ? LAISSEZ-NOUS AIDER
Voir GN-M562GLH Assistance Produit
Il suffit de choisir une option d'assistance parmi les icônes ci-dessous :
DT*rPrice*.*rPriceCent*
DT*rPromoPrice*.*rPromoPriceCent*
*discountMsg*
*retailerPricingText*
OBS_MEMBERSHIP_MSG DT*siblingMembershipPrice*
*obsMemberShipLinkEnd*

*reviewUploadText*